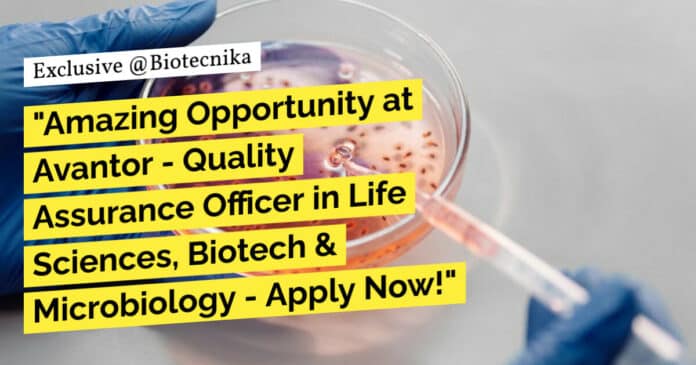

Avantor QA Officer Opportunity – Life Sciences, Biotech & Microbiology
The Opportunity:
Officer Quality Assurance is responsible for coordinating and Execute QMS activities and In-Process Quality Assurance (IPQA) program designed to ensure continuous production of products consistent with established standards by performing the following duties and responsibilities.
What we’re looking for:
- Education: Graduate/Post-graduate in Sciences-Life science/Biotechnology/ Microbiology/ Pharmacy
- Experience: 1-6 years of experience in Quality Assurance including cGMP, ISO, and regulatory Audits
- Industry: IVD preferred/ Medical devices
How you will thrive and create an impact:
- Responsible for Timely analysis of under test samples giving timely results
- Coordination with tollar for quality related issues and clarification
- Sampling and analysis for RM/Intermediate/Finished Goods.
- Ensure compliance of ATR.
- Assisting team in ISO implementation
- Knowledge of calibration, standard preparation, standardization and relevant documentation.
- Handling knowledge of HPLC,GC and wet analysis
- Give timely reports to SAP for result recording.
- Fill and update all documents.
- Zero accidents in the Quality operations.
- Achieving batch wise timelines, quantity and quality.
- Will train & supervise the working of all operators working in his dept. Will monitor the waste generated during operation.
- Will be member of the Emergency response team and will guide & train other team members in case of Emergency.
- Maintain ISO 9001:2008 and ISO/IEC 17025:2005, SAP, and other Quality system into department. Will maintain the analytical records / log sheets as per GMP & ISO guidelines
Apply now through this link.
Keywords: Avantor, QA Officer, Life Sciences, Biotech, Microbiology, Dehradun, Quality Assurance, cGMP, ISO, Regulatory Audits, IVD, Medical Devices. Avantor QA Officer Opportunity – Life Sciences, Biotech & Microbiology. Please ensure you are subscribed to the Biotecnika Times Newsletter and our YouTube channel to be notified of the latest industry news. Follow us on social media like Twitter, Telegram, Facebook


































Thankyou for sharing such informational blog with us, keep sharing
Best Indian Restaurant famous for Traditional Indian Foods in Dubai. Modern Indian Food of South, Punjab, West Foods & Hyderabadi Biryani.